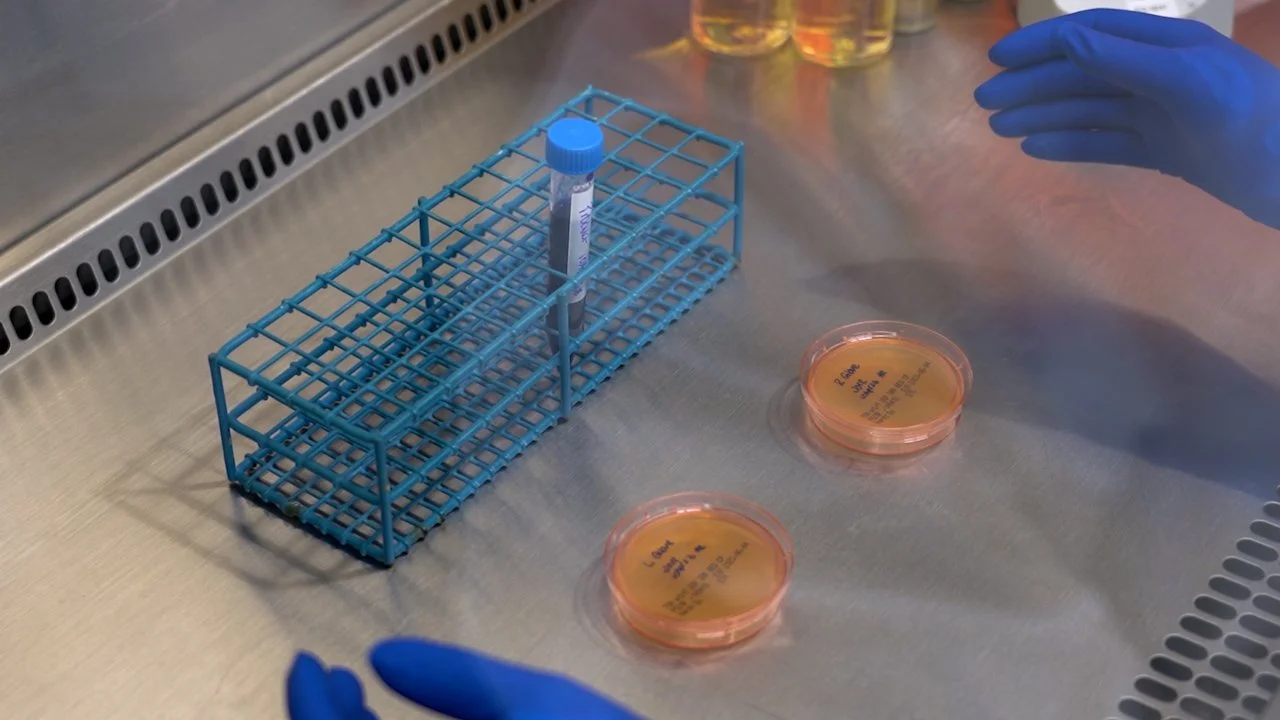

Game Documentaries






JoVE

RE Mentor





Fire Hose Games: The Series



Brafton



